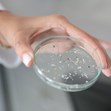

Най-модерният научен кораб в Европа пристигна в Русе
- Редактор: Мартин Руменов
- Коментари: 0
Научният екип започна събирането на проби от река Дунав за определени замърсители
Изследователският кораб REXDAN, който извършва мащабно изследване на конфигурацията и динамиката на река Дунав, успешно акостира край Русе днес. Корабът пристигна от румънския град Галац, като българският град е първата спирка от планираното европейско пътуване, съобщи д-р Нина Лазар от научния екип.
"Целта е да се съберат проби от река Дунав за определени замърсители и среща с представители на отделните държави, откъдето корабът ще премине", обясни тя, цитирана от БТА.
Плавателният съд е собственост на Университета "Долен Дунав" в румънския град Галац, който е координатор на проекта SUNDANSE. Корабът е закупен чрез този проект, финансиран по програма "Хоризонт Европа".
Девет специализирани лаборатории
На борда на REXDAN се намират девет специализирани лаборатории, които ще подпомогнат извършването на детайлни изследвания на река Дунав. Корабът разполага със системи за събиране и съхранение на проби, както и лаборатории за радиометрия, физико-химични анализи, мониторинг на биоразнообразието и батиметрия.
Резултатите от изследванията ще бъдат готови най-рано след година, според научния екип.
Партньорство с българска агенция
Изпълнителната агенция "Проучване и поддържане на река Дунав" в Русе участва като партньор в проекта SUNDANSE. През април тази година агенцията проведе първата измервателна кампания в България, обхващаща района на островите Голям Бръшлян и Мишка.
Европейска обиколка
След посещението в Русе корабът REXDAN ще продължи своето европейско турне с планирани спирки в Белград, Будапеща, Братислава и Виена до края на месеца. При обратното си пътуване изследователският кораб ще акостира в Нови Сад през август.
Успешното акостиране в Русе потвърждава статуса на града като важна спирка по дунавския маршрут и подчертава значението на региона за европейските научни изследвания.